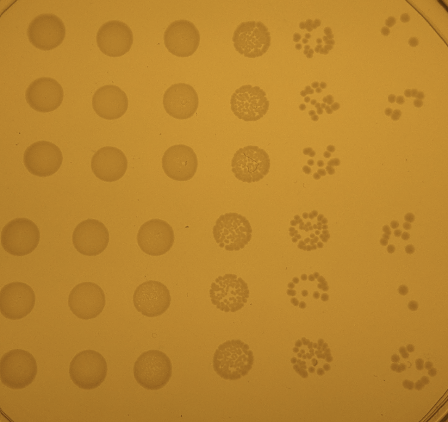

Author Cierra Sorin studies sexual consent. In this article, she focuses on graduate students to help prevent sexual violence and harassment on university campuses.
Author Archives: rmarroquin03
What’s killing the buzz? Investigating the multiple stressor hypothesis for bumble bee health
Author Austin Calhoun studies bumble bee health. He asks how bumble bees respond when they are exposed to a common fungicide and a pathogen at the same time.
Fruit flies shed light on how immune responses are regulated
Author Pooja KR studies the immune system using the fruit fly. She finds genes that help immune cells turn on when flies are infected with parasites.
How different are bird parasite communities between mountain ranges?
Author Dr. Lisa Barrow studies birds and the parasites that infect their blood. She looks to see if birds are exposed to similar parasites when they fly to different mountain ranges.
Less equals more: When does mortality lead to larger populations?
Author Zoey Neale studies how mortality might impact the size of a mosquito population. He removes individuals from the population and measures population growth.
Adopting new teaching standards: Fun or folly? Teacher professional knowledge on new science teaching standards in Illinois
Author Michael Burt studies how chemistry teachers build their teaching curricula. He looks at how Illinois teachers use Next Generation Science Standards (NGSS) in the classroom.
Looking under the hood: how warm temperatures affect gene processing in turtle eggs
Author Rosario Marroquin-Flores studies how incubation temperature effects turtles and how their genes are processed.
How your infection fights back: Bacterial defense against hypochlorous acid (HOCl)
Author Sadia Sultana studies how the body responds to a bacterial infection and how the invading bacteria defend themselves from the human immune system.
What can eggshell coloration tell us about female health and male behavior?
Author Kara Hodges studies eggshell coloration in house wrens to see if the color of the shells is related to female health. She also asks if male birds use shell color to decide how to care for their young.
Limited food intake and decision-making affects violence against Eswatini women
Author Brittnie Bloom explores how food insecurity and constrained agency contribute to intimate partner violence in Eswatini women and girls.